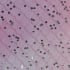

Kids First Giant Glitter Rain Boots
Regular price
$59.99
Sale price
$59.99
Regular price
$85.00
Unit price
per
Icon
If you're between sizes, we recommend sizing up.
Rainy days call for a little extra shine. The Kids First Giant Glitter Rain Boots are waterproof, crafted from natural rubber with an eye-catching glitter finish that catches the light with every step. A rounded toe gives little feet room to grow, while the flat, textured outsole keeps small explorers steady on wet ground. Soft lining and a pull-on design make gearing up quick and easy, so no adventure has to wait.
- Heel Height Range: Low
- Heel Type: Flat
- Toe Type: Round
- Closure: Pull-on
- Outsole Material: Leather
- Shaft Height : 7.48
- Calf Circumference: 12.13